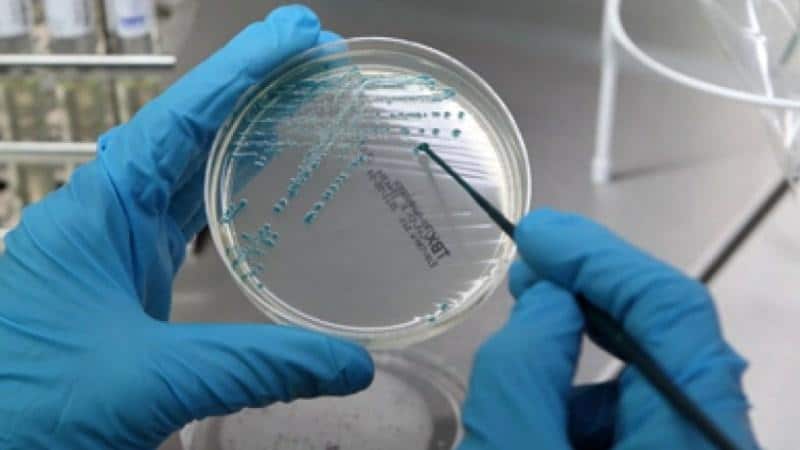

Исследование бактериологического мазка является стандартной процедурой, которую ежегодно, планово должен проходить каждый человек. Результаты анализа укажут на присутствие или отсутствие патогенных бактерий, грибков, наличие воспалительного процесса, и состояние микрофлоры влагалища у женщины.
Иногда результаты указывают на присутствие в мазке диплококка внеклеточно. Что означает эта бактерия в организме, и нужно ли проводить медикаментозное лечение?
Что такое внеклеточный диплококк
Такая бактерия, как диплококк, может существовать в двух стадиях: покоящаяся (внеклеточная) и репродуцирующая (внутриклеточная). У человека могут быть обнаружены обе стадии, или одна определенная. Покоящаяся стадия микроорганизма имеет такие особенности:
- Не растет, и не развивается, но способна оказывать пагубное воздействие на организм.
- Отличается от внутриклеточной бактерии отсутствием клеточного строения.
- Способна паразитировать, как внутриклеточный организм.
Внеклеточная форма жизни покрыта плотной оболочкой, которая защищает ее от низких температур, радиации и высушивания. Губительной средой для внеклеточного кокка являются антисептик, дезинфицирующие средства, ультрафиолет.
Внеклеточные бактерии в мазке всегда располагаются единично, не образуя цепочек. Если же диплококки в мазке имеют внутриклеточную форму, они располагаются рядом, и указывают на наличие гонококковой инфекции.
Многие пациенты интересуются: диплококки внеклеточно в мазке, что это такое, и как это лечить? Стоит отметить, что внеклеточная форма относится к семейству Lactobacteriaceae. Диплококк представляет собой округлую сферическую форму, и может быть окружен прозрачной оболочкой. В мазке могут быть обнаружены грамположительные и грамотрицательные бактерии.
Грамотрицательные типы становятся причиной развития такого заболевания, как гонорея, менингит. Грамположительный вызывает заболевания дыхательных путей: пневмококковая пневмония, синусит, отит.
Диагностика внеклеточного диплококка
Самым достоверным и результативным способом определить наличие микроорганизма и других патогенных бактерий является мазок на флору. Целью исследования является определение состояние микрофлоры, тяжесть воспалительного процесса, оценка чистоты влагалища и общее состояние здоровья.
У мужчин берется мазок из мочеиспускательного канала. Результаты исследования покажут состояние мочеполовой системы, признаки воспалительного процесса и присутствие патогенных бактерий. Если у пациента будут диплококки обнаружены внеклеточно, анализ придется пересдать, для уточнения диагноза.
Процедура подготовки к анализу и у мужчин и у женщин одинакова, и предполагает:
- Отказ от приема антимикробных и антибактериальных препаратов за 7 дней.
- Воздержаться от интимных отношений за 2 дня.
- Не пользоваться никакими кремами, спреями и мазями для половых органов за 2 дня до анализа.
- Гигиену половых органов провести за 12 часов до мазка.
- Не посещать туалет за 2 часа до анализа.
Результаты анализа буду готовы через 3-5 дней. Расшифровкой занимается только лечащий врач, который по полученным данным определит тип патогенного и условно-патогенного микроорганизма, и его концентрацию на слизистых мочеполовых органах.
На что указывают внеклеточные диплококки в мазке
Наличие диплококковв мазке указывает на нарушение нормальной микрофлоры. У здоровой женщины диплококки внеклеточной формы, могут находиться в минимальном количестве. Однако если местный иммунитет понизиться, или произойдет инфицирование другими бактериями, диплококк переходит в активную форму жизни и провоцирует гонококковую инфекцию.
Если были обнаружены внеклеточные диплококки в мазке у женщин, причины такого проявления могут быть такими:
- Частые спринцевания антисептическими растворами, которые вымывают полезную микрофлору.
- Неконтролируемый прием антибиотиков.
- Недостаточная гигиена половых органов.
- Незащищенные интимные отношения и частая смена партнера.
- Ношение тесного или синтетического белья.
Любая из этих причин может стать следствием дисбактериоза влагалища, который сопровождается зудом, жжением, обильными выделениями, болями при половом акте.
Присутствие внеклеточных диплококков в мазке пациента могут свидетельствовать о наличие таких патологий:
- Генитальный герпес – передается половым путем, и обнаруживается и у мужчин, и у женщин. Опасность инфекции в том, что клинические признаки проявляются только у 10% пациентов. Остальная категория узнает о диагнозе только после планового осмотра или при хронической стадии. Основными признаками герпеса являются жидкостные пузырьки на половых органах, зуд и жжение при мочеиспускании, устойчивая субфебрильная температура, слабость, признаки интоксикации организма.
- Уреаплазмоз – венерическое заболевание, которое нарушает здоровую микрофлору влагалища у женщин. У мужчин внеклеточные диплококки могут проявиться на фоне уреаплазмоза, бактерия которого локализуется в мочеиспускательном канале. При инфекции пациенты отмечают сильный зуд и болезненность, белесые выделения, общая слабость организма.
- Микоплазмоз –это инфекционное воспаление, которое проходит на фоне таких заболеваний, как воспаление уретры, эндометрит, гонорея, герпес, трихомониаз. Данная инфекция чаще встречается у женщин, и проявляется неприятными симптомами только на фоне сниженного местного иммунитета. В случае проявления микоплазмоза у мужчин, происходит воспалительный процесс предстательной железы и мочеиспускательного канала.
Непатогенные диплококки проявляются в анализах только при определенной патологии, поэтому так часто гинекологи назначают повторные анализы при наличии внеклеточной формы бактерии.
Причины появления диплококка
Внеклеточные диплококки в мазке у мужчин встречаются гораздо чаще, чем остальные бактерии. При наличии бактерии, лабораторными методами определяется ее тип: патогенный или условно-патогенный. После диагностики назначается адекватное лечение из учета полученных результатов и тяжести инфекции. Путь заражения диплококками зависит от патогенности бактерии:
Присутствие диплококк в мазке у мужчин и женщин указывает на наличие воспалительного процесса, который нужно определить и остановить.
Заключение
Многие пациенты обнаружив в анализе диплококки, пугаются, подозревая наличие гонореи. Однако гонококковая инфекция диагностируется только при присутствии внутриклеточных диплококков.
Внеклеточные бактерии могут проявляться при других патологических условиях, которые также неприятны и требуют медицинского внимания.
https://youtube.com/watch?v=Ok0OLeA1a50
Внеклеточные диплококки — это бактерии круглой формы, располагаются они по двое, иногда они окружены бактериальными капсулами. К ним относят также бактерию менингококка, пневмококка и гонококка.
Диплококки чаще обнаруживают в мазке при биологических исследования. Их присутствие уже может свидетельствовать о нарушениях микрофлоры половых органов.
Что же делать? Для начала советуем почитать статью с главного института паразитологии Российской Федерации. В данной статье раскрывается метод, с помощью которого можно почистить свой организм от паразитов, без вреда для организма. Читать статью >>>
Причины возникновения и пути заражения
Путь заражения зависит от патогенности бактерии:
- Внутриклеточная гонококковая бактерия проникает в организм через незащищенный секс, при совместном использовании индивидуальных предметов и внутриутробно. Гонорея является одним из самых неприятных заболеваний, которое при отсутствии лечения может повлечь неприятные последствия.
- Менингококковая бактерия является патогенной, и может проявиться в мазке. Основной путь заражения воздушно-капельный и бытовой. Инфекция поражает оболочку головного мозга и слизистую носоглотки. Без соответствующего лечения могут возникнуть серьезные осложнения с необратимыми процессами.
- Пневмококковая бактерия становится частой причиной пневмонии, особенно у маленьких детей и пожилых людей. Передается пневмококк воздушно-капельным и контактно-бытовым путем. При наличии пневмококка, у пациента могут быть обнаружены вне- и внутриклеточные диплококки.
Фото бактерий под микроскопом
Внеклеточные диплококки у мужчин
Чаще всего у мужчин диплококк вызывает гонорею. Для выявления заболевания берется мазок.
Мазок у мужчин берется из уретры. Если врач обнаружит данный диплококк, пациенту назначается повторная сдача бактериального анализа. Повторный мазок берут при помощи липкой полоски и стекла.
Процесс взятия образца для анализа из уретры
В большинстве случаев наличие в мазке внеклеточных диплококков у мужчины позволяют диагностировать гонорею. Помимо этого они могут являться причиной развития менингита, пневмонии и других опасных заболеваний. У мужчин эти заболевания встречаются чаще из-за беспорядочных половых контактов с непостоянными партнерами.
Симптомы менингита, пневмонии и гонореи следующие.
При менингите у больного:
- Заметна ригидность мышц;
- Он запрокидывает голову назад;
- Подгибает к животу колени;
- Отмечается высокая температура до 40 градусов °C;
- Лихорадка;
- Возможны галлюцинации;
- Рвота;
- Невыносимые головные боли;
- Больной может кричать от боли.
При развитии пневмонии:
- Поднимается высокая температура;
- Кашель;
- Жар;
- Возможны головные боли;
- Тяжесть;
- Одышка и прочее.
При гонореи первые симптомы будут:
- Гнойные выделения из половых путей;
- Общее недомогания;
- Воспаления мочеполовых путей с последующими болями внизу живота;
- Дискомфорт при мочеиспускании.
Диплококки в мазке у женщин
Что говорят врачи о лечении паразитов
Доктор медицинских наук, профессор Герман Шаевич Гандельман
Стаж работы: более 30 лет.
Занимаюсь обнаружением и лечением паразитов уже много лет. С уверенностью могу сказать, что паразитами заражены практически все. Просто большинство из них крайне трудно обнаружимы. Они могут быть где угодно — в крови, кишечнике, легких, сердце, мозге.
Паразиты в буквальном смысле пожирают вас изнутри, заодно отравляя организм. В итоге, появляются многочисленные проблемы со здоровьем, сокращающие жизнь на 15-25 лет.
Основная ошибка — затягивание! Чем раньше начать выводить паразитов, тем лучше. Если же говорить о лекарствах, то тут всё проблематично. На сегодняшний день существует только один действительно эффективный антипаразитный комплекс, это TOXIMIN. Он уничтожает и выметает из организма всех известных паразитов — от головного мозга и сердца до печени и кишечника. На такое не способен больше ни один из существующих сегодня препаратов.
В рамках Федеральной программы, при подаче заявки до 10 июня. (включительно) каждый житель РФ и СНГ может получить одну упаковку TOXIMIN БЕСПЛАТНО!
Существует три основных вида диплококков у женщин:
| Гонококки или венерические возбудители гонореи. | Эти бактерии, проникая в организм, образуют цепочки или бобовидные формы, которые способны вызывать жжение в области уретры во время мочеиспускания. Так же появляются желтые редкие выделения, и они сопровождаются неприятным запахом рыбы. Внутри влагалища такие бактерии могут вызывать нагноения области матки. |
| Менингококковые бактерии или малоподвижные организмы. | Они успешно разрушаются при снижении температуры тела. Локализуются они в носоглотке и на оболочках головного мозга. |
| Пневмококковые инфекции. | Для них характерны болезненные восприятия в области груди, боязнь света, частая дезориентация в пространстве. |
Чтобы определить тот или иной вид диплококка, приходя к доктору, все женщины должны в точности описывать свои ощущения, процесс мочеиспускания, присутствии необычных выделений и не свойственных беспокойств.
Опираясь на ваше самочувствие, доктор сможет вовремя назначить необходимые анализы. К таким анализам относится сдача мочи и мазок. Сам мазок берется из уретры, влагалища и околоматочного пространства.
Взятие мазка из влагалища и околоматочного пространства
Если в моче определяется присутствие большого количества лейкоцитов — это первый признак воспалительного процесса в теле. Мазки дают более точный результат при рассмотрении в микроскоп.
Заражение бактериями происходит по следующим причинам:
- Элементарное несоблюдение собственной гигиены;
- Применение антибиотиков без назначения лечащего врача и спринцевание без надобности;
- Начало половой жизни в раннем возрасте;
- Тесное синтетическое белье (очень близко граничит с анальным отверстием и является совершенным переносчиком бактерий во влагалище);
- Незащищенные половые акты с венерическим больным партнером;
- Проблемы с гормональным балансом;
- Частые спринцевания (многие считают процедуру полезной, однако она вымывает все полезные вещества и приводит к сильному раздражению в слизистой влагалища);
- Ношение синтетического нижнего белья;
- Падение иммунитета в организме;
- Частая смена половых партнеров.
Лечение
Как упоминалось выше внеклеточные диплококки являются причинами таких заболеваний, как менингит, пневмония и гонорея.
При менингите материалом для исследования служит спинномозговая жидкость, которую получают при помощи пункции. Процедура очень неприятная и болезненная, но она необходима для подтверждения диагноза и назначения своевременного лечения. Из спинномозговой жидкости лаборант готовит мазки, а также делает посев на питательные среды с содержанием крови.
Получение спинномозговой жидкости
Самым современным методом исследования является ПЦР, в результате этого анализа обнаруживается ДНК возбудителя. В любом случае, пока готовятся анализы больного необходимо госпитализировать, если есть подозрение на менингит, в этот период уже назначают антибиотики с широким спектром действия. После получение положительных результатов на менингококк, тактику лечения меняют.
Чаще всего врач назначает бензилпенициллин или ампициллин. Одновременно назначаются диуретики и успокаивающие средства. Больному вводятся водно- солевые растворы для нормализации состояния.
Если диагностику и лечение не провести вовремя то может произойти инфекционно- токсический шок вплоть до смертельного исхода.
Пневмония — одно из тяжелейших и длительных заболеваний, поражающего ткань легкого. В качестве диагностики при этом заболевании выступает рентгенография, но она показывает только наличие и локализацию очага, причина же при этом остается неизвестной.
Для определения возбудителя необходимо собрать мокроту для микроскопии и взять анализ крови. Если в мокроте при окраске по Граму обнаружатся парные шаровидные бактерии, то это точно диплококки, именно они являются самой частой причиной возникновения данного заболевания — это около 70% всех случаев.
Такой процент обусловлен тем, что пневмококк находится в дыхательных путях у каждого человека, а при возникновении стрессовых ситуация, переохлаждений, снижения иммунитета происходит его активация в качестве патогенной микрофлоры.
Чаще всего пневмония, вызванная пневмококком, возникает как осложнение после перенесенного гриппа или ангины. Если есть возможность, то лучше сделать полную диагностику, то есть необходимо сделать посев мокроты на питательные среды.
Лечение антибиотиками широкого спектра действия начинают сразу после госпитализации. После получения анализов врач уже выбирает препараты, которые будут действовать именно на бактерии, если обнаружены диплококки- лечение составит уже известный бензилпенициллин, курс которого продолжается 7-10 дней в зависимости от тяжести.
Также на пневмококки прекрасно действуют амоксиклав и цефтриаксон, которые можно назначить при обнаружении аллергии на препараты группы пенициллинов.
Лечение может корректироваться в зависимости от результатов. Во время лечения необходимо соблюдать постельный режим, а также особое внимание уделить питанию.
Обязательно нужно увеличить количество употребляемой за день жидкости, пусть это будет чистая вода, фруктовые соки, лучше всего приготовленные дома и содержащие большое количество витаминов. А употребление соли и рафинированных углеводов наоборот стоит значительно сократить.
В России существует прививка, которая может защитить от пневмококков, конечно у нее эффективность не 100%, а 70, но все же это является замечательной альтернативой.
Ее ставят тем людям, которые страдают частыми или хроническими заболеваниями легочной системы, больным с пороками сердца и сахарным диабетом, людям, которые находятся на химиотерапии или больны ВИЧ- инфекцией. По медицинским показаниям прививку повторяют через 5 лет.
Следующим заболеванием , которое вызываю диплококки является всем известная гонорея. Это заболевание, которое передается половым путем, женщины могут болеть скрытой формой и очень долго не подозревать о своем состоянии, а мужчины узнают о заражении в течении 72 часов. При гонорее бактерии поражают слизистые оболочки половых путей, проникая внутрь самой клетки.
Возбудитель гонореи в мазке гноя (окраска по Граму)
Источником инфекции является больной человек и заражение происходит только половым путем или же, когда ребенок проходит через родовые пути больной матери, тогда такое заболевание будет называться бленнореией. Для диагностики у женщины берут мазок из цервикального отдела, а у мужчин отделяемое уретры. Бактерии окрашиваются по Граму в красный цвет, они расположены попарно и заключены внутрь клетки.
Эти 3 признака уже позволяют врачу поставить диагноз- гонорея. Возможен также посев на питательные среды, но это длительный процесс и при данном заболевании им пользуются редко. Самым современным и чувствительным является, конечно же, ПЦР. Лечение гонореи очень простое, специалист назначает курс антибиотиков, обычно это цефтриаксон с азитромицином или доксициклином, лечение продолжается 7 дней.
Заболевания, вызванные диплококками поддаются лечению, главное, чтобы своевременно было проведено обращение к врачу-специалисту. Тогда возникновение осложнений после заболевания почти подходит к нулю.
Победить паразитов можно!
Советы наших читателей
Я избавилась от паразитов всего за неделю! Мне помогло средство, о котором я узнала из интервью с врачом-паразитологом.
Toximin® — средство от паразитов для детей и взрослых!
- Отпускается без рецепта врача;
- Можно использовать в домашних условиях;
- Очищает от паразитов за 1 курс;
- Благодаря дубильным веществам оздоравливает и защищает от паразитов печень, сердце, легкие, желудок, кожу;
- Избавляет от гниения в кишечнике, обезвреживает яйца паразитов благодаря моллекуле F.
Сертифицированное, рекомендуемое врачами-гельминтологами средство для избавления от паразитов в домашних условиях. Имеет приятный вкус, который понравится детям. Состоит исключительно из лекарственных растений, собранных в экологически чистых местах.
Сейчас действует скидка. Препарат можно получить бесплатно.
https://youtube.com/watch?v=N4IHKn18eHU
Здравствуйте, читатели сайта о паразитах Noparasites.ru. Меня зовут Александр Лигнум. Я автор данного сайта. Мне 23 года, я студент 5 курса Кемеровского государственного медицинского института. Специализация «Паразитолог». Консультация по телефону: +7 (495) 152-58-95. Подробнее об авторе>>
Лучшие истории наших читателей
Тема: Во всех бедах виноваты паразиты!
От кого: Людмила С. (ludmil64@ya.ru)
Кому: Администрации Noparasites.ru
Последние несколько лет чувствовала себя очень плохо. Постоянная усталость, бессонница, какая-то апатия, лень, частые головные боли. С пищеварением тоже были проблемы, утром неприятный запах изо рта.
А вот и моя история
Все это начало скапливаться и я поняла, что двигаюсь в каком-то не том направлении. Стала вести здоровый образ жизни, правильно питаться, но на мое самочувствие это не повлияло. Врачи тоже ничего толком сказать не могли. Вроде как все в норме, но я то чувствую, что мой организм не здоров.
Потом я пошла в одну дорогую клинику и сдала все анализы, так вот в одном из анализов у меня обнаружили паразитов. Это были не обычные глисты, а какой-то определенный вид, которым, по словам врачей, заражен практически каждый, в большей или меньшей степени. Вывести из организма их практически невозможно. Я пропила курс противопаразитных лекарств, которые назначили мне в той клинике, но результата почти не было.
Через пару недель я наткнулась на одну статью в интернете. Эта статья буквально изменила мою жизнь. Сделала все, как там написано и уже через несколько дней я почувствовала значительные улучшения в своем организме. Стала высыпаться намного быстрее, появилась та энергия, которая была в молодости. Голова больше не болит, появилась ясность в сознании, мозг стал работать намного лучше. Пищеварение наладилось, несмотря на то, что питаюсь я сейчас как попало. Сдала анализы и убедилась в том, что больше во мне никто не живет!
Кто хочет почистить свой организм от паразитов, причем неважно, какие виды этих тварей в вас живут — прочитайте эту статью, уверена на 100% вам поможет! Перейти к статье>>>
- Рядом с метро Кропоткинская
- Работаем каждый день с 9:00 до 20:00
- Стоимость консультации 900 рублей
Вы здесь
Диплококки в мазке
Диплококки в мазке представляют собой круглые бактерии (кокки), расположенные парами.
Существует множество разновидностей таких микроорганизмов.
Раньше их даже выделяли в отдельный род Diplococcus, но сегодня его нет.
Парами располагаются как возбудители опасных заболеваний, так и сапрофитная флора.
Виды диплококков
Для диагностики воспалительных процессов урогенитального тракта у пациентов берут мазки.
В них могут быть выявлены диплококки.
Их наличие может свидетельствовать о гонококковой инфекции.
Но не всегда расположенные парами бактерии – это гонококки.
Есть и другие микроорганизмы, которые могут выглядеть точно так же.
Большинство диплококков не встречаются в мочеполовой системе.
Но они могут выявляться в мазках анальных или орофарингеальных (изо рта).
Это как патогенные, так и сапрофитные бактерии.
В их числе:
- менингококки;
- пневмококки;
- Streptococcus pneumoniae;
- непатогенные нейссерии (Neisseria cinerea и другие).
Некоторые бактерии располагаются не только попарно.
Например, гемофильная палочка.
Бактериальные клетки в мазке могут выявляться отдельные, парные или большими скоплениями (по 3 и больше клетки).
Поэтому в случае обнаружения в мазке у мужчин диплококков не всегда можно ставить диагноз гонорея.
Нужны дополнительные признаки, отличающие его возбудителя от других бактерий.
В противном случае возможна гипердиагностика гонококковой инфекции.
Причины диплококков в мазке
Клиническое значение при взятии мазков из урогенитального тракта имеет только выявление в нем гонококков.
Это возбудители гонореи.
Данная инфекция передается половым путем.
Она вызывает воспалительные процессы уретры.
Может поражать и другие органы.
Нередко распространяется на предстательную железу.
Иногда вызывает воспаление яичек.
У женщин возможны вагиниты, цервициты, воспалительные процессы малого таза.
Причина заражения диплококками – это незащищенный секс.
Одновременно появляются такие признаки:
- инфильтрация уретры (при пальпации она определяется в виде плотного тяжа);
- дискомфорт при мочеиспускании;
- болевые ощущения во время полового акта;
- покраснение меатуса.
Если инфекция распространяется на предстательную железу, отмечается тяжесть в промежности или боль.
Она может иррадиировать в крестец, прямую кишку.
При воспалении яичек и придатков отмечается боль в мошонке.
Возможно её покраснение, сглаживание складчатости.
Из уретры инфекция может распространяться на шейку мочевого пузыря.
Чаще это случается у женщин.
Тогда отмечаются сильные и частые позывы к мочеиспусканию.
Диплококки могут распространяться на влагалище, цервикс, матку и придатки.
Тогда появляется диспареуния, боль в животе, гнойно-геморрагические выделения.
Анализы при диплококках в мазке
Для диагностики используют микроскопию.
Мазок берут у мужчин из уретры.
У женщин также из половых путей.
Только урогенитальные мазки подходят для диагностики гонореи.
В анальных и оральных мазках может содержаться множество других диплококков.
Их можно перепутать с гонококками, что становится причиной ошибочного диагноза.
Первое, на что обращает внимание врач при микроскопическом исследовании мазка, это появление большого количества лейкоцитов.
При воспалительном процессе их больше 5-10 в поле зрения.
К тому же, количество лейкоцитов превышает число эпителиальных клеток.
Задача врача состоит в том, чтобы идентифицировать их как гонококки по трем параметрам:
На вид бактерии выглядят как зерна кофе.
Они расположены по двое и обращены вогнутыми сторонами внутрь.
По Граму гонококки окрашиваются отрицательно.
То есть, в розовый цвет.
Если же врач после окраски препарата по Граму видит фиолетовые шаровидные бактерии, то это другие диплококки.
Решающее значение имеет расположение бактерий.
При гонорее диплококки располагаются не только вне клеток, но и внутри них.
Они проникают внутрь лейкоцитов и эпителиоцитов.
Для других диплококков это не характерно.
Диагноз гонорея не ставится, если при микроскопическом исследовании препарата не обнаруживаются внутриклеточно расположенные бактерии.
Посев на диплококки
Более информативным исследованием является культуральный метод.
Он обладает самой высокой специфичностью среди всех методик.
А потому почти не дает ложноположительных результатов.
Именно посев используется в судебно-медицинской экспертизе, как самый точный метод.
Он позволяет дифференцировать различные виды диплококков.
Суть метода состоит в следующем:
1. Берется мазок.
2. Помещается в питательную среду.
3. Культивируется в оптимальных для бактерий условиях.
4. После роста колоний проводится идентификация микроорганизмов для точного установления их вида.
Показания для посева:
- обследование детей;
- контроль излеченности;
- обследование женщин (у них диплококки редко выявляются при микроскопии);
- подозрение на изолированные орофарингеальные или анальные формы гонореи;
- резистентность к терапии (для оценки чувствительности к антибиотикам);
- сохраняющиеся симптомы гонореи при отсутствии диплококков в мазке по данным микроскопии;
- сексуальное насилие.
Растут колонии около 24 часов.
Если через 3 суток они не появляются, результат посева считается отрицательным.
Идентификация проводится по морфологическим и биохимическим признакам.
Колонии гонококков выглядят так:
При дальнейшей инкубации в течение последующих суток они становятся плоскими, а также увеличиваются в размере до 3 мм.
Обычно трудностей с идентификацией гонококков не возникает, если биоматериал для посева взят с урогенитального тракта.
А вот если мазки брались из ануса или рта, могут вырасти на питательной среде и другие гонококки.
Они несколько отличаются по тинкториальным свойствам.
Колонии менингококков имеют голубой цвет.
Непатогенные нейссерии образуют белые колонии.
Тем не менее, такие показатели как размер, цвет, форма меняются, в зависимости от условий культивирования и состава питательной среды.
Поэтому данные показатели не могут быть определяющими при идентификации диплококков.
Необходимы дополнительные тесты.
Оцениваются сахаролитические свойства бактерий.
Применяется оксидазный тест.
Он помогает определить цитохром-С оксидазу.
Для этого наносят тетраметил-р-фенилендиамин в виде однопроцентного раствора на подозрительную колонию.
Если через несколько секунд появится синее окрашивание, реакция положительная.
Это означает, что данный фермент присутствует.
В случае положительного теста диагноз гонорея считается подтвержденным.
Идентификация вида бактерий может быть проведена путем оценки сахаролитических свойств.
Но для этого требуется выделения чистой культуры диплококков.
То есть, проводится пересеивание колонии на другую питательную среду, чтобы на ней не было других бактерий.
После этого проводятся ростозависимые или ростонезависимые тесты.
В последнее время чаще используются ростонезависимые тесты.
Они позволяют получить результат в течение нескольких часов.
Для этого используются коммерческие наборы.
В случае ферментации сахаров цвет среды меняется с красного на желтый.
Такой результат считается положительным.
Он свидетельствует о наличии гонококков в питательной среде.
Что делать если в мазке появились диплококки
При обнаружении диплококков, если установлен диагноз гонорея, врачи сразу же назначают лечение.
Его основными целями являются:
- уничтожение бактерий – виновников воспалительного процесса;
- предотвращение распространения возбудителя в другие органы;
- предотвращение заражения контактных лиц;
- профилактика осложнений (абсцессов, генерализованной гонореи и т.д.);
- устранение симптомов заболевания.
Лечение должно проводиться под контролем венеролога.
Терапией гонококковой инфекции также занимаются гинекологи и урологи.
При обнаружении диплококков существует высокая вероятность того, что у этого же пациента имеются другие инфекции.
Они выявляются больше чем у половины больных.
Поэтому рекомендовано обследование на сопутствующие ЗППП.
В противном случае лечение может быть неэффективным.
Клиническое выздоровление после курса антибиотикотерапии часто не наступает по причине наличие других половых инфекций.
У пациента берут мазок из уретры.
Его исследуют методом ПЦР на хламидиоз, трихомониаз.
Берут кровь на ВИЧ и сифилис.
Обязательно подлежат обследованию и лечению все контактные лица.
Партнеры пациента должны быть уведомлены о наличии у него венерического заболевания.
Они приходят в клинику и тоже обследуются на диплококки.
Если гонорея не обнаружена в мазке, проводится ПЦР.
В случае недавнего полового контакта с носителем гонококковой инфекции проводится превентивное лечение.
Только если все партнеры одновременно излечиваются, прерывается эпидемиологическая цепочка заболевания.
В противном случае происходит реинфицирование, и пациент вскоре может вернуться в клинику с теми же симптомами.
Как лечить диплококки в мазке
Основная цель терапии – это эрадикация диплококков.
Назначаются препараты, которые уничтожают этих бактерий.
В основном используется цефтриаксон.
Этот препарат угнетает транспептидазу.
Тем самым он нарушает синтез мукополисахарида – компонента клеточной стенки диплококков.
Препарат стабилен в присутствии бета-лактамаз.
Поэтому к нему редко встречаются случаи резистентности у гонококков.
Вводится препарат внутримышечно.
Пероральных форм не существует, так как цефтриаксон почти не всасывается в желудочно-кишечном тракте.
Максимальная концентрация в плазме крови достигается спустя 3 часа после введения препарата.
Используют его 1 раз в сутки, по 0,25 г.
Одного укола достаточно для лечения неосложненных форм:
- урогенитальной;
- анальной;
- орофарингеальной гонореи.
Если гонококки обнаруживаются в конъюнктиве глаза, цефтриаксон назначают в разовой дозе 1 грамм.
При отсутствии осложнений возможно лечение гонореи пероральными цефалоспоринами.
Его назначают в разовой дозе 400 мг.
Осложненные или хронические формы гонококковой инфекции требуют более длительной терапии.
Используемые дозировки антибиотиков выше.
Назначают цефтриаксон по 0,5 грамм в сутки.
Инъекции делают внутримышечно или внутривенно.
Курс лечения продолжается около 2 недель.
Его длительность зависит от тяжести состояния пациента, распространенности инфекции.
В некоторых случаях проводится лечение в условиях стационара.
Госпитализация необходима в таких случаях:
- системные проявления заболевания;
- угроза прерывания беременности у женщин;
- необходимость проведения лапароскопического или другого инвазивного исследования.
В условиях стационара может применяться вместо цефтриаксона цефотаксим.
Его назначают по 1 грамму внутривенно, 3 раза в сутки.
Контрольные анализы на диплококки
После курса лечения обязательно выполняется лабораторный контроль.
Необходимо убедиться, что диплококков в мазке больше нет.
Анализы сдают на 2 день после окончания антибиотикотерапии, а затем ещё раз через 14 дней.
Лабораторный контроль может проводиться при помощи ПЦР или бак посева.
Микроскопическое исследование не обладает достаточной чувствительностью, чтобы точно подтвердить излеченность.
Потому что в микроскоп диплококки выявляются, только если их много, и симптомы заболевания ярко выражены.
При малом количестве гонококков они не попадают в поле зрения.
Если ПЦР дает негативный результат, человек считается излечившимся.
В случае, когда исследование положительное, необходимо повторное лечение диплококков в мазке.
Возможные причины отсутствия эффекта:
- неправильный прием пациентом препаратов (если он лечился в домашних условиях);
- формирование резистентности к применяемому антибиотику и диплококков;
- повторное заражение (если не пролечен половой партнер).
Для повторного лечения диплококков в мазке у женщин назначают препараты других фармакологических групп.
Может применяться спектиномицин.
Его назначают по 2 грамма внутримышечно, 2 раза в день.
Оптимальной тактикой в случае положительного результата контрольного исследования на диплококки является бактериологический посев.
В ходе исследования определяется чувствительность гонококка к различным антибактериальным препаратам.
Это позволяет врачу подобрать тот антибиотик, который с высокой вероятностью приведет к эрадикации возбудителя.
Профилактика диплококка в мазке
Чтобы в ваших мазках никогда не было диплококков, необходимо сделать следующее:
- ограничить количество половых партнеров;
- не заниматься сексом с людьми, у которых имеются признаки воспаления мочеполовых органов;
- всегда использовать презерватив.
После секса можно делать экстренную профилактику.
Для этого необходимо обработать гениталии Мирамистином.
Его необходимо ввести в уретру, влагалище.
Если был анальный или оральный секс – прополоскать горло и ввести в прямую кишку.
Делать это нужно в течение 2 часов после интимного контакта.
Если вы не уложились в это время, желательно обратиться к врачу и получить превентивную терапию.
Оно состоит в промывании уретры катетером.
Вводятся антисептические растворы на основе ионов серебра.
Выполняется также инъекция цефтриаксона.
Небольшая однократно введенная доза антибиотика позволяет предотвратить заражение.
Диплококки в мазке: к кому обратиться
При обнаружении гонококков следует обратиться к венерологу.
Вы можете получить помощь в нашей клинике.
Мы предлагаем такие услуги:
- обследование для подтверждения диагноза (ПЦР, посев);
- оценка распространенности инфекционного процесса;
- обследование на сопутствующие ЗППП;
- лечение гонококковой инфекции;
- контроль излеченности.
У нас используются современные схемы лечения.
Они позволяют избавиться как от острой, так и от хронической формы гонореи.
Проводится эффективное лечение осложненных форм гонококковой инфекции.
При выявлении диплококков в мазке обращайтесь к автору этой статьи – венерологу в Москве с многолетним опытом работы.
«>